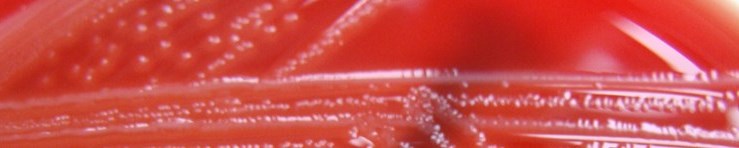

Nombre: Joaquin V. Martinez-Suarez
About me: Investigador Titular del Departamento de Tecnología de Alimentos (INIA)
Phone: +34 913474027
Localization: Tecnologia de Alimentos, INIA, Autovia A-6 km 7.5, 28040 Madrid
Proyectos en marcha
Proyectos recientes
Artículos publicados en revistas científicas
Artículos publicados en revistas divulgativas